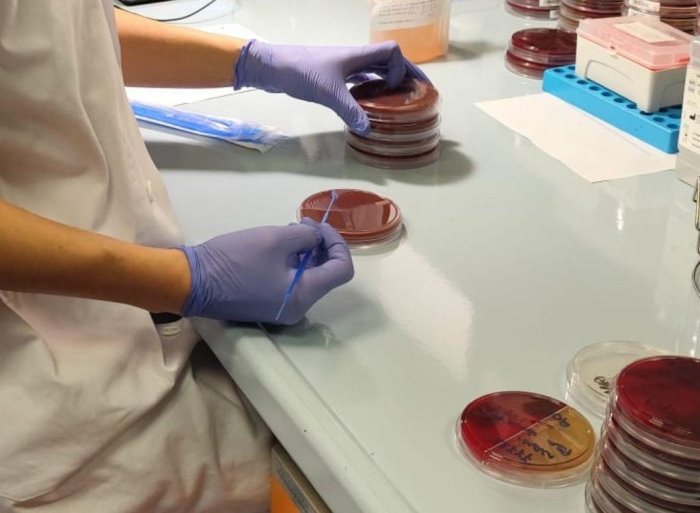

Reparto
Malattie Infettive
Prime visite e primi accessi urgenti: Prenotabili al Numero Verde Regionale
Visite di controllo e profilassi pre-esposizione (PreP)
Su appuntamento: malattieinfettive@policlinico.mi.it
Per informazioni:
malattieinfettive@policlinico.mi.it
Tel. 02.5503.4770
Screening Test HIV
dal lunedì al venerdì (non festivi)
dalle 8.00 - 12.00 accesso libero
ATTIVITA' AMBULATORIALE
Lun-Ven dalle ore 08.30 alle 17.00
Segreteria
Tel. 02.5503.4770
malattieinfettive@policlinico.mi.it
Malattie Infettive
AmbulatoriAccesso da via Francesco Sforza 35 - Al punto informazioni, svoltare a destra, proseguire dritto, percorrere la discesa tenendo la sinistra, seguire indicazioni per ingresso Malattie Infettive – Ambulatori 1° piano
Malattie Infettive
DegenzeLe malattie infettive sono diventate negli ultimi anni un problema sanitario emergente. Il ruolo dello specialista infettivologo in un grande ospedale ad alta specializzazione è fondamentale. La presenza di un esperto nella gestione dei chemioterapici antinfettivi può portare benefici sia in termini di uso razionale di farmaci, minore abuso delle terapie innovative ad alto costo, prevenzione degli effetti collaterali sui pazienti, migliore prognosi e quindi degenze meno complicate.
Il Policlinico sta organizzando le nuove attività ambulatoriali e di reparto per la diagnosi e la cura delle malattie infettive. L’attività delle Malattie Infettive si caratterizza per la gestione delle urgenze infettivologiche, delle infezioni complesse, della stewardship antibiotica e per il controllo delle terapie antivirali, in particolare modo riguardo alle terapie antiretrovirali e la gestione del paziente HIV.
Nello specifico:
- Degenza ordinaria: ricovero di pazienti affetti da patologie contagiose o isolamenti protettivi per pazienti fragili. Si svolge attività di diagnosi e trattamento delle infezioni complesse, con particolare riferimento alle infezioni sostenute da germi multi-farmaco resistenti e alle infezioni life-treathening.
- Percorsi infettivologici: dedicati alla gestione clinica e al trattamento delle differenti patologie di interesse infettivologico:
- prevenzione, diagnosi e cura dei pazienti affetti da patologia infettiva cronica (HIV e infezioni da virus epatotropi)
- percorsi multidisciplinari condivisi per la gestione dei pazienti immunodepressi: pazienti sottoposti a trapianto d'organo solido, trapianto di midollo osseo, terapie con farmaci immunomodulanti, chemioterapia
- percorsi multidisciplinari per la gestione delle infezioni complesse: infezioni osteoarticolari, infezioni cardio-polmonari, infezioni da sostenute da patogeni MDR.
È presente un Centro Prelievi dedicato per i soli pazienti seguiti “cronicamente” e un Servizio di distribuzione farmaci per quei pazienti seguiti, che necessitino di farmaci a dispensazione ospedaliera (antiretrovirali, anti-HCV). I percorsi si integrano con la presenza di diversi specialisti (microbiologo, cardiologo, traumatologo, trapiantologo, gastroenterologo, psichiatra, psicologo, chirurgo proctologo, nutrizionista…) per la diagnosi e la gestione delle comorbidità nei pazienti affetti da patologia infettiva cronica, in particolare nei pazienti affetti da HIV.
- Attività MAC/Day Service: rivolta ai pazienti che necessitano di terapia anti-infettiva per via infusionale. L’attività consente di poter effettuare terapia antibiotiche BID senza dover ricorrere all’ospedalizzazione del paziente. Il servizio MAC/Day Service è rivolto inoltre a pazienti che necessitano di cure complesse o di procedure diagnostiche invasive (rachicentesi, biopsie, medicazioni avanzate).
- Consulenza infettivologica.
- Ricerca clinica: ideazione, sviluppo e gestione di studi clinici spontanei e sponsorizzati nell'ambito delle Malattie Infettive, anche come occasione di offerta ai pazienti di terapie innovative.
- Sepsi e shock settico
- Infezioni nel paziente immunocompromesso
- Patologie infettive sostenute da patogeni multi-farmaco resistenti e da patogeni ad alta diffusività
- Gestione delle emergenze infettive
- Gestione delle infezioni complesse
- Gestione della stewardship antibiotica
- Gestione dei pazienti con infezioni virali croniche (HIV, HCV, HBV...)
Staff
Laura Alagna 


















Coordinatore infermieristico
Maria Tabini
Aggiornato alle 08:43 del 09/04/2026